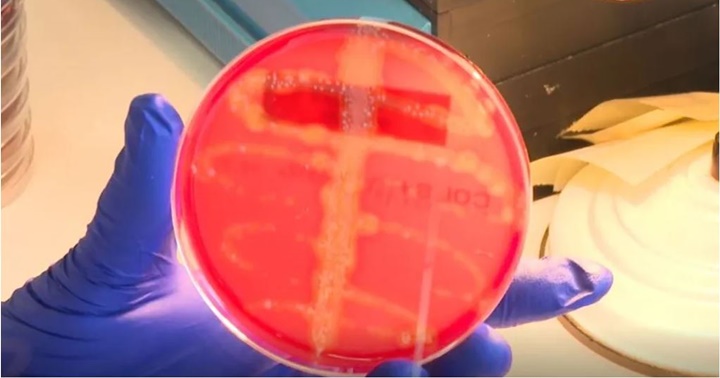

En los últimos 30 años pocos antibióticos han llegado a la clínica. El descubrimiento de la lariocidina, un antibiótico que actúa de manera diferente a los existentes, es un avance importante.
Por primera vez en décadas, los investigadores han descubierto una nueva clase de antibióticos que podrían combatir eficazmente las superbacterias, algunas de las bacterias más resistentes a los medicamentos en el planeta.
Y todo por casualidad. La molécula se encontró en muestras de suelo recolectadas del jardín de un técnico de laboratorio. El descubrimiento demuestra que «hay cosas increíblemente interesantes escondidas a simple vista», afirma Kim Lewis, microbióloga de la Universidad Northeastern en Boston, Massachusetts, quien no participó en la investigación.
Este fue el primer paso en lo que podría ser el desarrollo de nuevos medicamentos antimicrobianos con el potencial de curar enfermedades mortales, desde neumonía hasta infecciones del tracto urinario.
El equipo de investigadores de la Universidad McMaster en Hamilton (Canadá) presenta sus resultados en un estudio publicado en la revista ‘Nature’.
ABC de España Salud
